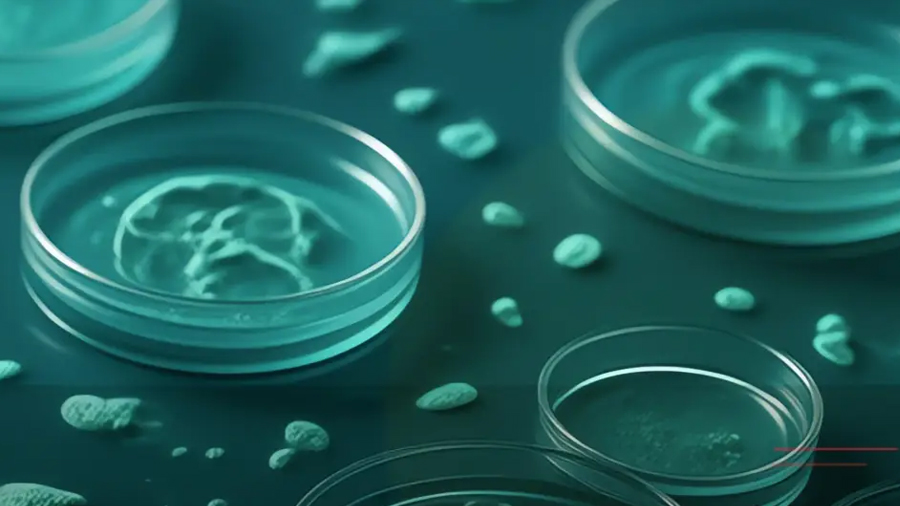

El microorganismo, hallado a mil metros de profundidad, logra degradar el 30 % de poliuretano en apenas dos semanas, reduciendo drásticamente la toxicidad ambiental
En un avance que podría transformar la lucha contra la contaminación global, investigadoras del Instituto de Biotecnología (IBt) de la UNAM han identificado una bacteria capaz de descomponer materiales sintéticos en tiempo récord. El equipo, liderado por Liliana Pardo López y Nallely Magaña Montiel, centró su estudio en la cepa Stutzerimonas frequens, un microorganismo adaptado a las condiciones extremas del fondo marino.
Un hallazgo en las profundidades
La bacteria fue recolectada a mil metros bajo el nivel del mar en el Golfo de México. Debido a que esta región convive naturalmente con hidrocarburos, los microorganismos locales han evolucionado para «alimentarse» de compuestos complejos. Según los resultados publicados en el Marine Pollution Bulletin, esta cepa demostró una eficiencia inédita:
- Capacidad: Degrada hasta el 30 % del poliuretano en solo 15 días.
- Versatilidad: Forma parte de un grupo selecto de bacterias capaces de actuar sobre distintos tipos de plásticos comerciales.
Reducción de toxicidad y potencial biotecnológico
Uno de los puntos más destacados de la investigación es la seguridad del proceso. Al realizar pruebas con embriones de pez cebra, las científicas confirmaron que la acción de la bacteria reduce la mortalidad de estos organismos en un 80 %, revirtiendo la letalidad de los residuos plásticos.
Además, el proceso de degradación no solo elimina basura, sino que genera subproductos que podrían utilizarse para crear bioplásticos o compuestos con propiedades antimicrobianas.
El futuro: «Sobres de bacterias» para el hogar
A pesar del éxito, las investigadoras señalan que el reto continúa, ya que los plásticos comerciales contienen aditivos y colorantes que dificultan una limpieza total. La meta final del equipo es diseñar consorcios microbianos (mezclas de varias bacterias) que puedan descomponer todos los componentes del plástico de manera integral.
La Dra. Pardo López vislumbra un futuro práctico para este descubrimiento: el desarrollo de productos comerciales, como sobres de bacterias, que permitan a cualquier persona tratar sus residuos plásticos y reducir su impacto ambiental de forma sencilla y segura.
Fuente: eldiariodesonora.com.mx